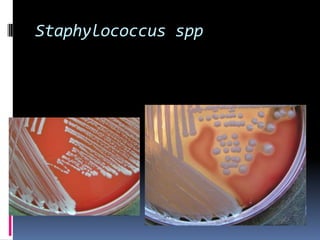
Staphylococcus spp
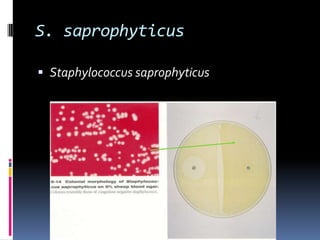
S. saprophyticusStaphylococcus saprophyticus
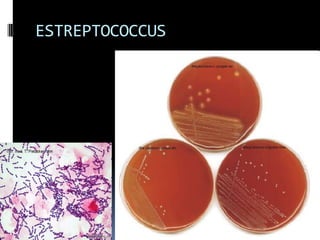
ESTREPTOCOCCUS
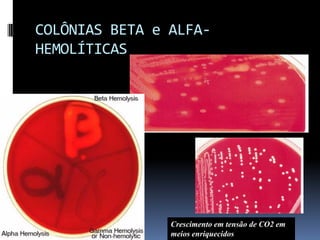
COLÔNIAS BETA e ALFA-HEMOLÍTICASCrescimento em tensão de CO2 em meios enriquecidos
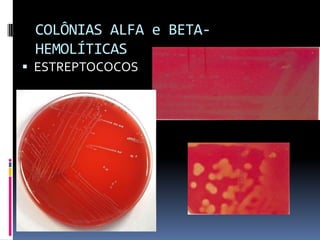
COLÔNIAS ALFA e BETA-HEMOLÍTICASESTREPTOCOCOS
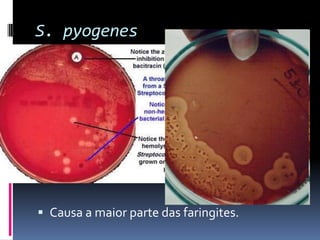
S. pyogenesCausa a maior parte das faringites.
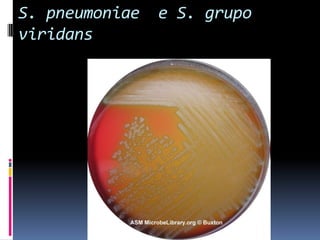
S. pneumoniae  e S. grupo viridans
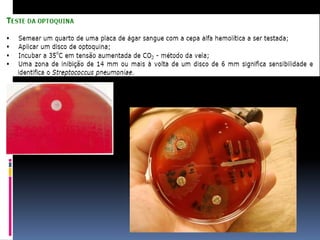
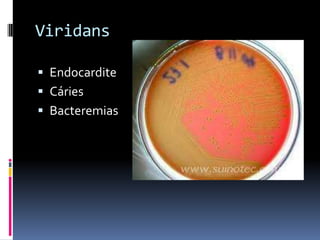
ViridansEndocarditeCáriesBacteremias
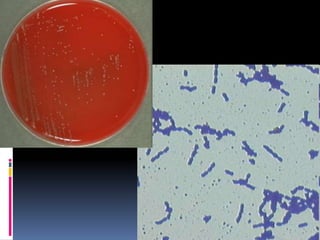
Aula 5 - M

O documento descreve características de cocos gram-positivos, incluindo Staphylococcus aureus e espécies, Streptococcus pyogenes, S. agalactiae, S. pneumoniae e Enterococcus. Detalha testes para identificação como catalase, coagulase e bile-esculina. Discute importância clínica e padrões de sensibilidade a antimicrobianos.